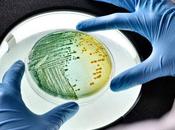
Color heces ¿qué puede significar?

Saludconsultas
 Descripción
Descripción
compartido
MIS BLOGS
-
Salud Consultas | Actualidad de Salud, Bienestar y Nutrición
https://www.saludconsultas.com/
Salud Consultas | El Blog de la Salud, toda la información sobre Salud, Bienestar, Nutrición, Suplementos Deportivos, artículos de entrenamientos, curiosidades de nuestro mundo, dietas saludables, avances de la informática médica y su Impacto en los sistemas de salud... además de participar en la discusión de la salud y compartir sus experiencias. Pregunta a expertos médicos y aprende la manera de mejorar su salud. Lee artículos médicos y noticias de la salud de última hora. Únete a la comunidad de la salud más grande en la web.
ÚLTIMOS ARTÍCULOS (5914)
-
El exceso de foto en las redes sociales puede aumentar el narcisismo

Inicio Noticias de Ciencia Psicología / Psiquiatría El exceso de foto en las redes sociales puede aumentar el narcisismoNoticias de CienciaPsicología /... Leer el resto
Publicado el 03 diciembre 2018 SALUD Y BIENESTAR -
Dieta del huevo para bajar de peso

Inicio Dietas Dieta del huevo para bajar de pesoDietasDieta del huevo para bajar de pesoPor Equipo de redacción - 2 December, 2018ShareFacebook Twitter Google+... Leer el resto
Publicado el 02 diciembre 2018 SALUD Y BIENESTAR -
La píldora del día después, efectos secundarios: lo que realmente puede esperar...

Inicio Embarazo Antes de quedar embarazada La píldora del día después, efectos secundarios: lo que realmente puede esperar...EmbarazoAntes de quedar... Leer el resto
Publicado el 02 diciembre 2018 SALUD Y BIENESTAR -
Dieta para aumentar masa muscular y perder grasa simultaneamente

Inicio Aumentar Masa Muscular Dieta para aumentar masa muscular y perder grasa simultaneamenteAumentar Masa MuscularDietasDieta para aumentar masa muscular y... Leer el resto
Publicado el 02 diciembre 2018 SALUD Y BIENESTAR -
¿Podría usted ser anémica? Los síntomas de la anemia en las mujeres

Inicio Salud de la Mujer ¿Podría usted ser anémica? Los síntomas de la anemia en las mujeresSaludde la Mujer¿Podría usted ser anémica? Los síntomas... Leer el resto
Publicado el 01 diciembre 2018 SALUD Y BIENESTAR -
4 razones por las que tus dedos se vuelven morados

Inicio Condiciones de salud Trastornos musculoesqueléticos en Respuestas Médicas 4 razones por las que tus dedos se vuelven moradosCondiciones de saludTrastorno... Leer el resto
Publicado el 01 diciembre 2018 SALUD Y BIENESTAR -
Orgasmo seco: ¿por qué no produce semen cuando llega al clímax?

Inicio Salud de la Familia La salud de los hombres en Respuestas Médicas Orgasmo seco: ¿por qué no produce semen cuando llega al clímax? Leer el resto
Publicado el 01 diciembre 2018 SALUD Y BIENESTAR -
Color de las heces ¿qué puede significar?
Inicio Salud Trastornos gastrointestinales Color de las heces ¿qué puede significar?SaludTrastornos gastrointestinalesColor de las heces ¿qué puede... Leer el resto
Publicado el 01 diciembre 2018 SALUD Y BIENESTAR -
5 Causas de dolor abdominal que aumenta con el movimiento

Inicio Condiciones de salud Desórdenes gastrointestinales en Respuestas Médicas 5 Causas de dolor abdominal que aumenta con el movimientoCondiciones de... Leer el resto
Publicado el 01 diciembre 2018 SALUD Y BIENESTAR -
Tendinitis de rodilla: tratamiento y síntomas

Inicio Salud Articular Tendinitis de rodilla: tratamiento y síntomasSaludArticularTendinitis de rodilla: tratamiento y síntomasPor Equipo de redacción - 1... Leer el resto
Publicado el 01 diciembre 2018 SALUD Y BIENESTAR -
¿Cómo tratar una infección por hongos en el pene?

Inicio Salud de la Familia La salud de los hombres en Respuestas Médicas ¿Cómo tratar una infección por hongos en el pene? Leer el resto
Publicado el 30 noviembre 2018 SALUD Y BIENESTAR -
El uso del azúcar por parte de las células cancerígenas es la clave de su...

Inicio Noticias de Ciencia Biología / Bioquímica El uso del azúcar por parte de las células cancerígenas es la...Noticias de CienciaBiología /... Leer el resto
Publicado el 30 noviembre 2018 SALUD Y BIENESTAR -
Este circuito cerebral es clave tanto para la depresión como para la adicción

Inicio Noticias de Ciencia Neurología / Neurociencia Este circuito cerebral es clave tanto para la depresión como para la...Noticias de CienciaNeurología /... Leer el resto
Publicado el 30 noviembre 2018 SALUD Y BIENESTAR -
El tiempo frente a la pantalla interrumpe el sueño al reiniciar los relojes...

Inicio Salud Trastornos Oculares El tiempo frente a la pantalla interrumpe el sueño al reiniciar los...SaludTrastornos OcularesEl tiempo frente a la... Leer el resto
Publicado el 30 noviembre 2018 SALUD Y BIENESTAR -
El ejercicio regular puede mantener el cuerpo décadas más joven

Inicio Deportes Entrenamientos y Ejercicios Físicos El ejercicio regular puede mantener el cuerpo décadas más jovenDeportesEntrenamientos y Ejercicios... Leer el resto
Publicado el 30 noviembre 2018 SALUD Y BIENESTAR -
Efectos secundarios de las terapias de reemplazo hormonal (TRH)

Inicio Salud de la Familia La salud de la mujer en Respuestas Médicas Efectos secundarios de las terapias de reemplazo hormonal (TRH)Salud de la FamiliaLa... Leer el resto
Publicado el 29 noviembre 2018 SALUD Y BIENESTAR -
Efectos secundarios de metformina (Glucophage) en mujeres y hombres

Inicio Respuestas Médicas Medicamentos y Terapia en Respuestas Médicas Efectos secundarios de metformina (Glucophage) en mujeres y hombresRespuestas... Leer el resto
Publicado el 29 noviembre 2018 SALUD Y BIENESTAR -
El ejercicio puede prevenir ataques al corazón en personas sana

Inicio Salud Enfermedades del Corazón El ejercicio puede prevenir ataques al corazón en personas sanaSaludEnfermedades del CorazónDeportesEntrenamientos y... Leer el resto
Publicado el 29 noviembre 2018 SALUD Y BIENESTAR -
Dolor lumbar: la radiofrecuencia pulsada puede ser la respuesta

Inicio Noticias de Ciencia Investigación Médica Dolor lumbar: la radiofrecuencia pulsada puede ser la respuestaNoticias de CienciaInvestigación MédicaDolor... Leer el resto
Publicado el 29 noviembre 2018 SALUD Y BIENESTAR -
¿Quién descubrió la insulina?

Inicio Salud Sistema linfático y endocrino ¿Quién descubrió la insulina?SaludSistema linfático y endocrino¿Quién descubrió la insulina? Leer el resto
Publicado el 29 noviembre 2018 SALUD Y BIENESTAR
